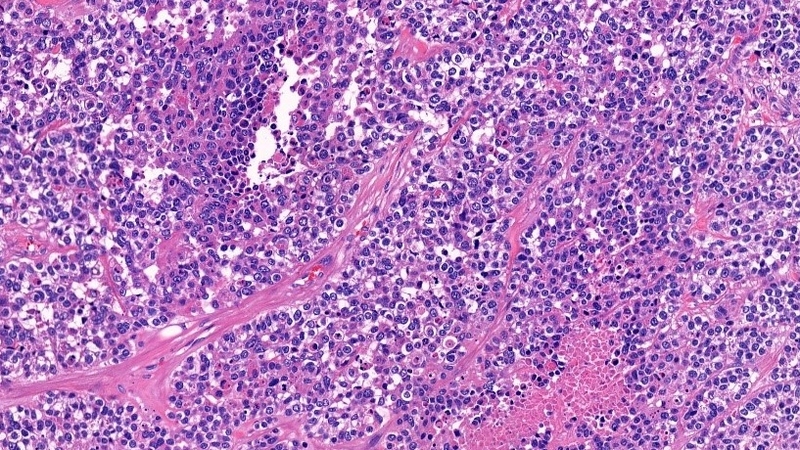
Giải phẫu bệnh có vai trò gì 2

Từng làm ở Viện ISDS, nhiều năm cộng tác với CDC Thái Nguyên triển khai dự án phòng chống HIV/AIDS, 2 năm cộng tác với WHO.
Ngọc Ánh
03/05/2024
Mặc định
Lớn hơn
Giải phẫu bệnh được xem là một chuyên ngành khoa học nghiên cứu các tổn thương và mối quan hệ giữa việc biến đổi hình thái của các mô, tế bào với các rối loạn trên cơ quan, bộ phận của cơ thể. Từ đó, giúp các bác sĩ chẩn đoán và xác định phương pháp điều trị thích hợp nhất đối với các tổn thương đó.
Giải phẫu bệnh là những phương pháp được dùng để phân tích mẫu bệnh phẩm và mô tế bào, nhằm mục đích chẩn đoán và tìm ra nguyên nhân gây bệnh, đặc biệt là các bệnh lý ác tính. Để hiểu rõ hơn về vấn đề này, hãy theo dõi bài viết dưới đây của Nhà thuốc Long Châu!
Giải phẫu bệnh là những vấn đề liên quan đến chẩn đoán bệnh thông qua việc phân tích các mẫu bệnh phẩm và mô tế bào. Các mẫu bệnh phẩm này được lấy từ các cơ quan và bộ phận bị bệnh của cơ thể.
Các bác sĩ chuyên khoa và kỹ thuật viên sẽ tiến hành xử lý, làm tiêu bản và phân tích dưới kính hiển vi. Kết quả phân tích sẽ được dùng để chẩn đoán và đánh giá tình trạng bệnh. Từ đó, các bác sĩ sẽ đưa ra phác đồ và hướng điều trị phù hợp.
Chính vì thế, giải phẫu bệnh được xem là một chuyên ngành khoa học nghiên cứu các tổn thương và mối quan hệ giữa việc biến đổi hình thái của các mô, tế bào với các rối loạn trên cơ thể để chẩn đoán và xác định phương pháp điều trị thích hợp nhất đối với các tổn thương đó.

Xét nghiệm giải phẫu bệnh đóng vai trò quan trọng trong việc chẩn đoán bệnh đặc biệt là với các bệnh lý ác tính như ung thư,... Các mẫu bệnh phẩm sẽ được lấy hoặc sinh thiết trong quá trình nội soi, phẫu thuật hoặc sinh thiết bằng kim.
Một số loại xét nghiệm giải phẫu bệnh được dùng phổ biến hiện nay là xét nghiệm mô bệnh học, xét nghiệm tế bào học, xét nghiệm hóa mô miễn dịch và xét nghiệm sinh thiết tức thì.
Mô từ cơ quan hoặc bộ phận bị bệnh sẽ được lấy bằng phương pháp sinh thiết nội soi (sinh thiết qua dạ dày, thực quản,...), sinh thiết kim dài (ung thư vú, gan, phổi, thận,...) hoặc lấy trong quá trình phẫu thuật. Những mẫu mô bệnh phẩm này sẽ được bảo quản trong dung dịch formol và được chuyển đến các phòng xét nghiệm để được phân tích, giải phẫu.
Kết quả của xét nghiệm này giúp bác sĩ chẩn đoán được bản chất của bệnh là lành tính hay ác tính cũng như mức độ xâm nhập của bệnh. Ngoài ra, xét nghiệm mô bệnh học còn giúp xác định mức độ lan rộng của các tế bào ung thư.
Phương pháp này có độ chính xác cao nhưng thời gian cho kết quả khá lâu, thông thường là sau khoảng 3 ngày.
Xét nghiệm tế bào học có thể được dùng để chẩn đoán ung thư cổ tử cung, ung thư tuyến vú,... Phương pháp này có thể xác định khối u là lành tính hay ác tính ngay từ khi khối u có kích thước còn rất nhỏ.
Các bác sĩ sẽ dùng một cây kim nhỏ chuyên dụng để lấy mẫu tế bào. Tế bào này sau đó sẽ được cố định trên lam kính, nhuộm màu và soi trên kính hiển vi. Những thay đổi bất thường của tế bào này sẽ được nhận thấy thông qua việc phóng đại trên kính hiển vi. Kết quả này sẽ được dùng để đánh giá và chẩn đoán bệnh.
Ưu điểm của phương pháp xét nghiệm tế bào học là thời gian thực hiện khá nhanh, khoảng từ 30 - 60 phút, dễ thực hiện, giúp tiết kiệm chi phí và cho kết quả có độ chính xác khá cao.
Tuy nhiên, phương pháp này chỉ mang tính chất định hướng và độ chính xác của phương pháp này còn phụ thuộc vào một số yếu tố khác như trình độ chuyên môn, thao tác kỹ thuật và kinh nghiệm của các bác sĩ, kỹ thuật viên.

Chẩn đoán hóa mô miễn dịch là phương pháp dựa trên nguyên lý miễn dịch, kháng nguyên đặc hiệu sẽ kết hợp với kháng thể đặc hiệu của nó. Các kháng nguyên này sẽ được lấy từ các mô bệnh phẩm của người bệnh.
Xét nghiệm này thường được sử dụng đối với các trường hợp khối u kém biệt hóa, làm cho việc chẩn đoán mô bệnh học khó xác định và thực hiện được. Đặc biệt, phương pháp này thường được áp dụng trong các trường hợp chẩn đoán đột biến gen ở một số bệnh ung thư như gen EGFR, gen P53 ở bệnh nhân ung thư phổi, gen Her2 ở bệnh nhân ung thư vú,... Việc xác định đúng căn nguyên gây bệnh sẽ giúp các bác sĩ tìm được hướng điều trị đúng.
Xét nghiệm chẩn đoán hóa mô miễn dịch được chỉ định khi:
Phương pháp này thường được áp dụng ngay trong quá trình đang phẫu thuật. Các bác sĩ phẫu thuật sẽ tiến hành lấy mẫu bệnh phẩm khi đang phẫu thuật và chuyển đến phòng xét nghiệm. Các chuyên gia sẽ nhanh chóng xử lý và phân tích xem đó là u lành tính hay ác tính.

Ưu điểm của xét nghiệm sinh thiết tức thì là cho kết quả nhanh sau khoảng 15 - 30 phút.
Các xét nghiệm giải phẫu bệnh có vai trò quan trọng và được ứng dụng rộng rãi trong y học nhằm mục đích:
Tóm lại, giải phẫu bệnh là các phương pháp xét nghiệm được dùng để sàng lọc, chẩn đoán và xác định mức độ bệnh thông qua các mẫu bệnh phẩm lấy từ quá trình phẫu thuật, sinh thiết kim hoặc nội soi. Xét nghiệm mô bệnh học, tế bào học, hóa miễn dịch và sinh thiết tức thì được đánh giá là những giải pháp khá hiệu quả được các bác sĩ sử dụng trong quá trình chẩn đoán và điều trị bệnh.
Hy vọng những thông tin mà Nhà thuốc Long Châu cung cấp trong bài viết này sẽ có ích với bạn. Đừng quên nhấn theo dõi trang web của chúng tôi để cập nhật sớm nhất những thông tin sức khỏe hay ho và bổ ích. Được đồng hành cùng bạn và gia đình trên con đường chăm sóc sức khỏe là niềm vinh hạnh của Long Châu.
Xem thêm:
Dược sĩ Đại học Nguyễn Tuấn Trịnh
Từng làm ở Viện ISDS, nhiều năm cộng tác với CDC Thái Nguyên triển khai dự án phòng chống HIV/AIDS, 2 năm cộng tác với WHO.